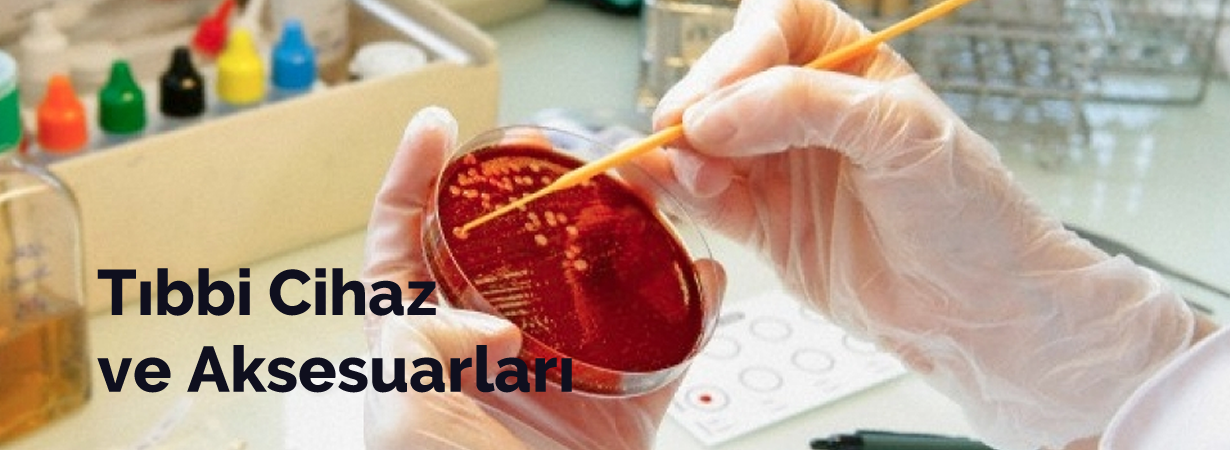

Medikal
ATİLLA KİMYA SAN. VE TİC.LTD.ŞTİ.
İOSB MAH. DERSANKOOP SAN.SİT. TRİOS 2023 B BLOK NO/ 47 BAŞAKŞEHİR / İSTANBUL
Galeri 7 Fotoğraf

Firma Hakkında
Tıbbi ve ortopedik alet ve cihazların toptan ticareti konularında hizmet vermektedir. Her türlü tıbbi malzemenin ithalini,ihracını,yurt içinde ve yurt dışında toptan ve perakende ticaretini yapmak yaptırmak...